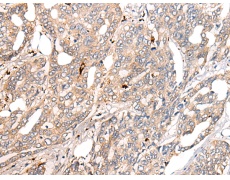
一抗

中文名稱:兔抗COL11A1多克隆抗體
|
Background: |
This gene encodes one of the two alpha chains of type XI collagen, a minor fibrillar collagen. Type XI collagen is a heterotrimer but the third alpha chain is a post-translationally modified alpha 1 type II chain. Mutations in this gene are associated with type II Stickler syndrome and with Marshall syndrome. A single-nucleotide polymorphism in this gene is also associated with susceptibility to lumbar disc herniation. Multiple transcript variants have been identified for this gene. |
|
Applications: |
ELISA, IHC |
|
Name of antibody: |
COL11A1 |
|
Immunogen: |
Fusion protein of human COL11A1 |
|
Full name: |
collagen type XI alpha 1 chain |
|
Synonyms: |
STL2; COLL6; CO11A1 |
|
SwissProt: |
P12107 |
|
ELISA Recommended dilution: |
5000-10000 |
|
IHC positive control: |
Human thyroid cancer and Human liver cancer |
|
IHC Recommend dilution: |
25-100 |


 購物車
購物車 幫助
幫助
 021-54845833/15800441009
021-54845833/15800441009